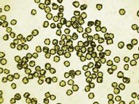

Company
News
PlasmaChem Prize for the Best Poster at NANOFORUM 2012 |
|
|
CIAMIE 2012 and Nanotoxicology 2012, China |
|
|
NANO KOREA 2012 |
|
|
We invite you to Diamond and Carbon Materials Conference |
|
|
New product line in the catalogue |
|
|
PlasmaChem invites you to Nanoforum 2012, Rome |
|
2012-07-04 PlasmaChem is happy to be a sponsor and the presentor and welcome you at Nanoforum 2012 conference opening on 24 September 2012 in Rome, Italy. Nanoforum is not a scientific conference, but a particular event for technology transfer from research to production and business: an opportunity to catch up on all the latest applications in the field of micro and nanotechnology, to get in touch with potential business partners. More information available at www.nanoforum.it. The CEO of PlasmaChem Dr. Alexey Kalachev will give the presentation there on the 24th of September 2012. |
PlasmaChem invites you to NANOTEXNOLOGY 2012 |
|
|
PlasmaChem announces it has signed a distributor agreement with EMAXWIN TECHOLOGY CORP., Taiwan R.O.C. |
|
|
PlasmaChem announces it has signed a distributor agreement with Beijing AnWeiAn Lab Equipment Co.,Ltd ., People's Republic of China |
|
|
PlasmaChem at GTAI meeting in Tel Aviv |
|
2011-12-12 From 12 to 15 of December 2011 a delegation of West-German companies including PlasmaChem (Berlin), BASF (Schwarzheide) and ITAVA (Potsdam) will visit the capital of Israel. In addition to the safety technologies (disaster control, crisis management and protection of the civilian population), the visit and the subsequent industry forum will also focus on the chemical industry. (Full article)
|
PlasmaChem announces it has signed a distributor agreement with Reinste in India |
|
2011-08-03 PlasmaChem announces it has signed a distributor agreement with Reinste Nano Ventures Pvt. Ltd. for distribution of nanomaterials in India. Reinste is a company associated with the Indian Nanotechnology consortium. Its core business is based on the import and marketing of nanomaterials products of PlasmaChem in India. The distribution agreement will allow PlasmaChem to win access to the local R&D and industrial customers. More information about Reinste is available at www.reinste.com |
Particles 2011 conference |
|
2011-05-18 PlasmaChem is happy to be once again a sponsor of Particles 2011 conference, which will be held in the
home-city of the company – Berlin. Once again the best poster will receive a 500 USD PlasmaChem prize!
|
Nanotex 2011 conference |
|
2011-05-13 PlasmaChem is happy to become a sponsor of Nanotex 2011 conference held in Thessaloniki, Greece on
12-15 July 2011. The NN is the Internationally established world-class event in Nanosciences and Nanotechnologies
(N&N) that focuses on the latest advances on N&N and promotes profound scientific discussions between scientists
and researchers from different disciplines.
|
Nanomaterials 2011 conference and exhibition |
|
2011-05-13 PlasmaChem GmbH is sponsoring Nanomaterials 2011 conference and exhibition held in London, UK on 8-9 June 2011,
which will atract over 600 leading scientists in the fields of commercialisation of nanotechnology.
|
The 11th International euspen Conference |
|
2011-05-06 PlasmaChem GmbH is happy to become a sponsor of The 11th International euspen Conference, which will be
focused on the latest advances and market developments in precision processes and manufacturing, as well as
fabrication, metrology and cutting-edge materials in the precision, micro and nano engineering sectors.
|
PlasmaChem announces it has signed a distributor agreement with Bioportugal Lda |
|
2011-05-01 PlasmaChem announces it has signed a distributor agreement with Bioportugal Lda for distribution of
nanomaterials in Portugal. Bioportugal is a company whose core business is based on the import and marketing of
pharmaceuticals and diagnostics. The distribution agreement will allow PlasmaChem to win access to the local R&D
and industrial customers. Bioprtugal will profit from expanding its activities in the sector of nanotechnology.
|
LED Summit |
|
2011-05-01 PlasmaChem GmbH takes part in LED summit in Berlin, 4-5 May 2011 presenting new developments in light converters for LED applications. Download a flyer. |
PlasmaChem signs distributor agreement with Comercial Química Massó, S.A. |
|
2011-04-15 PlasmaChem announces it has signed a distributor agreement with Comercial Química
Massó, S.A. (CQM) for distribution of nanomaterials in Spain. CQM is one of the leading companies
in Spain commercializing chemical specialities in sectors of agriculture, gardening, home products, glass,
additives etc.
|
3rd Congress “Secure Identity” – International Conference |
|
2011-04-06 PlasmaChem presents the new developments and applications of the new technique and device “NanoLuminograph” at the 3rd congress “Secure Identity”. You can download an extended abstract at www.plasmachem.com/download/nanoluminograph_extended_abstract_de_3rd_congress_secure_idnt.pdf |
Sponsoring ImagineNano, Bilbao, Spain |
|
2011-04-01 PlasmaChem GmbH is glad to be a sponsor of Imagine Nano conferences and exhibition on 11-14 April 2011.
ImagineNano will comprise in 15.000 m2 several conferences in parallel, a huge exhibition and a Social component
where everyone can meet and greet Nanotechnology side by side.
|
New Catalogue of Nanomaterials 2011-2012 |
|
2011-03-13 — PlasmaChem is happy to announce the immediate availability of the new catalogue of Nanomaterials
and Related products / 2011-2012:
|
Condolences to people of Japan |
|
2011-03-11 — With great sadness have we learned of devastating earthquake and tsunami in Japan.
|
Novel nanoparticles for applications in photoresists are developed in the frame of NAMIROS project |
|
2010-12-31 — PlasmaChem congratulates the participants of Namiros BMBF Projekt targeted on the development of novel photoresists for holography applications. Novel zirconia and titania nanoparticles with a high refractive index developed by PlasmaChem in the frame of the project, allowed to realize the ambitious goals. You can learn more about Namiros by visiting its website. You can purchase the mentioned material (PL-ZrO-HPB) through our catalogue. |
Project HINAMOX launched |
|
2010-10-19 — Kick-off meeting of the EU-Project HINAMOX was held today in San-Sebastian (Spain).
The project is aiming on a deeper understanding of nanoparticles influence on environment and human health.
|
PlasmaChem at the 24th Meeting of Medical Technology |
|
2010-07-01 Dr. Alexey Kalachev, CEO of PlasmaChem presented the companies’ recent developments in the area of bio-resolvable implants. You can download the abstract of presentation at www.plasmachem.com/download/intelligente-implantate_berlin_2010.pdf. |
PlasmaChem poster award for Particles 2010 |
|
2010-05-01 PlasmaChem is sponsoring the Particles 2010, and is happy to announce additionally two 500 USD awords for the best posters. Particles 2010 is one of the eldest and most prominent conferences on colloids, which will take part this year in Florida on 22-25 May 2010. |
PlasmaChem at Gold 2009 conference |
|
2009-04-30 PlasmaChem takes part at conference Gold 2009 (26-29 July 2009, Heidelberg, Germany) presenting the new developments in the area of additives for metal electroplating electrolytes. You can download the poster at www.plasmachem.com/download/poster_gold_2009_plasmachem.pdf |
PlasmaChem at RusNanotech 09 |
|
2009-10-08 — PlasmaChem thanks all visitors of the Second Nanotechnology International
Forum Rusnanotech'2009 exhibition held in Moscow, 06-08 October 2009.
|
PlasmaChem at Nanotech Europe 2009 |
|
2009-09-30 — PlasmaChem thanks all visitors of nanotech Europe conference, who visited its exhibition stand and conference presentation on the topic “Tribology investigation of silver and goldelectroplated in presence of nano-diamondsand nano-alumina”. The copy of presentation can be downloaded at this link. |
Exhibition AMITEC 2009 |
|
PlasmaChem cordially invites you to stand "G38", Hall 2 in AMITEC 2009 exhibition in Leipzig, Germany from 28 March to 1 April 2009, where it will present a novel additive to engine oils based on NanoDiamonds - ADDO®. ADDO has been an outcome of almost 15 years of research work on nano-enabled technologies performed at PlasmaChem.
|
Highly Dispersed Stable Carbon Nanotubes (CNT) Solutions And Powders |
|
2008-01-19 — PlasmaChem GmbH (Berlin, Germany) has developed a novel method for the production of highly stable colloidal solutions of carbon nanotubes (CNT). The multistep process consists of a deep purification of CVD-produced nanotubes, a partial modification of their surface with carboxylic or sulfonic groups followed by a modification of the surface with a specially synthesized polymeric ligand. The final CNT dry powders can be easily re-suspended in aqueous or organic media yielding highly stable colloidal solutions with concentrations up to 30 mg/mL.
|
Highly Dispersed Single-Digit NanoDiamonds Solutions and Powders |
|
2008-01-19 — PlasmaChem GmbH (Berlin, Germany) has developed a novel method for the production of highly stable colloidal solutions of single-digit NanoDiamonds (SDND). The process consists of a deep purification and multistep chemical disintegration of NanoDiamonds, produced from nanodiamonds soot of dry detonation. The absence of mechanical disintegration ensures the highest purity of the final material. The SDND solution can be dried; dry powders can be easily re-suspended in aqueous media yielding highly stable colloidal solutions with very high concentrations. The average size of the particles in colloidal solution is ca. 10 nm.
|
ADDO®: Cooperation with Nanotec-Professional |
|
After many years of research, PlasmaChem GmbH is starting marketing of a new product. The motor oil additive on the base of nanodiamonds and nanographite is leading to the enormous smoothing of the moving engine parts, reducing strongly friction and mechanical losses. Besides, nanodiamonds get impregnated into the metallic surface and keep oil film on it. The result: increase of the engine power, normalization of the compression and strong decrease of fuel consumption.
|
Exhibition Nanosolutions 2008 |
|
We cordially invite you to our stand "D5" in NANOSOLUTIONS 2008 exhibition in Frankfurt/Main from 11st to 13rd November 2008.
|
Best poster award at Particles 2008 |
|
PlasmaChem GmbH cordially congratulates the winners of the PlasmaChem best poster award at Particles 2008 (http://nanoparticles.org/Particles2008/#winners) conference in Orlando.
|
PlasmaChem supports world largest Nanoparticles conference |
|
PlasmaChem GmbH will be a corporate sponsor of NanoParticles 2008 conference, which will take part on May 10-13, 2008 in Orlando, USA.
|
Exhibition Powtech 2007 |
|
|
New Product |
|
PlasmaChem GmbH is announcing a novel product - engine oil additive on the base of nanodiamonds and nanographite. More details on ADDO is available at www.addo-oil.com |
New Service: Surface DSC-like Measurements |
|
Surface temperature transition ("DSC-like") analysis service using novel concept realised in Nano-Luminograph is available. |
Absolute Sedimentation Gauge |
|
Absolute Sedimentation Gauge has been developed for studying sedimentation stability of nano- and micro-suspensions in any desired medium. |
Nanomaterials Online Catalogue |
|
Order our products ONLINE with the new NANOMATERIALS ONLINE CATALOGUE.
|
Download Publications |
|
Download publications about PlasmaChem and LensWista. |
New Company LensWista GmbH |
|
|
New Adress |
|
Since start of 2005 we moved to Federal Technopark "Berlin-Adlershof" because of better technological and investment circumstances.
|

 2012-09-04 All academic participants to the “poster” session of Nanoforum 2012 will have the opportunity to win the competition advertised by the sponsor of the event, a prestigious German company Plasmachem.
2012-09-04 All academic participants to the “poster” session of Nanoforum 2012 will have the opportunity to win the competition advertised by the sponsor of the event, a prestigious German company Plasmachem.  2012-08-31 Following a very successful International Chemical Advanced Materials (CIAMIE 2012) being held 29-31 Aug. 2012, PlasmaChem represented by AnWeiAn Lab Equipment Co. Ltd. will be happy to meet you on Nanotoxicology 2012 event on 4-7 Sept. 2012. Read further about
2012-08-31 Following a very successful International Chemical Advanced Materials (CIAMIE 2012) being held 29-31 Aug. 2012, PlasmaChem represented by AnWeiAn Lab Equipment Co. Ltd. will be happy to meet you on Nanotoxicology 2012 event on 4-7 Sept. 2012. Read further about  2012-08-16 NANO KOREA 2012 started today! The largest nanotechnology event of South Korea accomodating almost 3000 scientists at the conference, and over 350 companies at the exhibition under the slogan "Nanotechnology, the Frontiers of Innovation” has started today in Seoul. This year’s event is special as it is
2012-08-16 NANO KOREA 2012 started today! The largest nanotechnology event of South Korea accomodating almost 3000 scientists at the conference, and over 350 companies at the exhibition under the slogan "Nanotechnology, the Frontiers of Innovation” has started today in Seoul. This year’s event is special as it is 2012-07-30 DIAMONDS of different sizes from the tiny ones of 100 nm to the giants of 0.6 millimeter. Check in the
2012-07-30 DIAMONDS of different sizes from the tiny ones of 100 nm to the giants of 0.6 millimeter. Check in the  2012-07-02 PlasmaChem is happy to be a sponsor and the presentor and welcome you to the NANOTEXNOLOGY 2012 conference opening today in Thessaloniki, Greece. The NANOTEXNOLOGYis the Internationally established world-class event in that focuses on the latest advances on nanotechnology and promotes profound scientific discussions between scientists and researchers from different disciplines. More information available at
2012-07-02 PlasmaChem is happy to be a sponsor and the presentor and welcome you to the NANOTEXNOLOGY 2012 conference opening today in Thessaloniki, Greece. The NANOTEXNOLOGYis the Internationally established world-class event in that focuses on the latest advances on nanotechnology and promotes profound scientific discussions between scientists and researchers from different disciplines. More information available at  2012-06-01 PlasmaChem announces it has signed a distributor agreement with Emaxwin Technology Corp. for distribution
of nanomaterials and ADDO in Taiwan R.O.C. Emaxwin is a professinol distributor company for nano products, Optical, Automotive, Additive and Chemical materials. Emaxwin has four major divisions: Electronic material, Nano products, Automotive, Crystal materials. The distribution agreement will allow PlasmaChem to win access to the local R&D and industrial customers.
More information about Emaxwin is available at
2012-06-01 PlasmaChem announces it has signed a distributor agreement with Emaxwin Technology Corp. for distribution
of nanomaterials and ADDO in Taiwan R.O.C. Emaxwin is a professinol distributor company for nano products, Optical, Automotive, Additive and Chemical materials. Emaxwin has four major divisions: Electronic material, Nano products, Automotive, Crystal materials. The distribution agreement will allow PlasmaChem to win access to the local R&D and industrial customers.
More information about Emaxwin is available at  2011-12-01 PlasmaChem announces it has signed a distributor agreement with Beijing AnWeiAn Lab Equipment Co.,Ltd. for distribution
of nanomaterials and ADDO in China. AnWeiAn Lab Equipment is a professinol distributor company for laboratory equipment, laboratory and engineering goods. The distribution agreement will allow PlasmaChem to win access to the local R&D and industrial customers. AnWeiAn Lab Equipment will benefit strongly by entering the new market of nanotechnology.
More information about AnWeiAn Lab Equipment is available at
2011-12-01 PlasmaChem announces it has signed a distributor agreement with Beijing AnWeiAn Lab Equipment Co.,Ltd. for distribution
of nanomaterials and ADDO in China. AnWeiAn Lab Equipment is a professinol distributor company for laboratory equipment, laboratory and engineering goods. The distribution agreement will allow PlasmaChem to win access to the local R&D and industrial customers. AnWeiAn Lab Equipment will benefit strongly by entering the new market of nanotechnology.
More information about AnWeiAn Lab Equipment is available at 
 Foto: Stephen Schmidt (Fraunhofer IBM, forward field), winner of the PlasmaChem Prize for best poster, after receiving PlasmaChem Prize for Best Poster from Melanie Martin (Particles Conference, left). Surrounding are some of the judges (from right) Alla Synytska, Volker Mailaender, Gleb Sukhorukov, Valerie Ravaine (mostly occluded by Dr. Schmidt), and Geoff Bothun. Out of the field to the right was Sven Holger Behrens, and Dieter Trau was unavailable.
Foto: Stephen Schmidt (Fraunhofer IBM, forward field), winner of the PlasmaChem Prize for best poster, after receiving PlasmaChem Prize for Best Poster from Melanie Martin (Particles Conference, left). Surrounding are some of the judges (from right) Alla Synytska, Volker Mailaender, Gleb Sukhorukov, Valerie Ravaine (mostly occluded by Dr. Schmidt), and Geoff Bothun. Out of the field to the right was Sven Holger Behrens, and Dieter Trau was unavailable.
 Foto: Anatoly Chubais (head of the Russian Nanotechnology Corporation) and Sergei Ivanov
(First Deputy Prime Minister of the Russian Federation) are interested in ADDO® - additive to
engine oils invented by PlasmaChem. Dr. Sicking explains details.
Foto: Anatoly Chubais (head of the Russian Nanotechnology Corporation) and Sergei Ivanov
(First Deputy Prime Minister of the Russian Federation) are interested in ADDO® - additive to
engine oils invented by PlasmaChem. Dr. Sicking explains details.



 Our booth at Exhibition Powtech 2007 caused great interest, especially in the areas of quantum dots and customized plasma coatings.
Our booth at Exhibition Powtech 2007 caused great interest, especially in the areas of quantum dots and customized plasma coatings.
 New company LensWista GmbH based on developments of PlasmaChem in area of contact lenses of super-long wear, was founded in Leverkusen together with Bayer IndustryService.
New company LensWista GmbH based on developments of PlasmaChem in area of contact lenses of super-long wear, was founded in Leverkusen together with Bayer IndustryService.